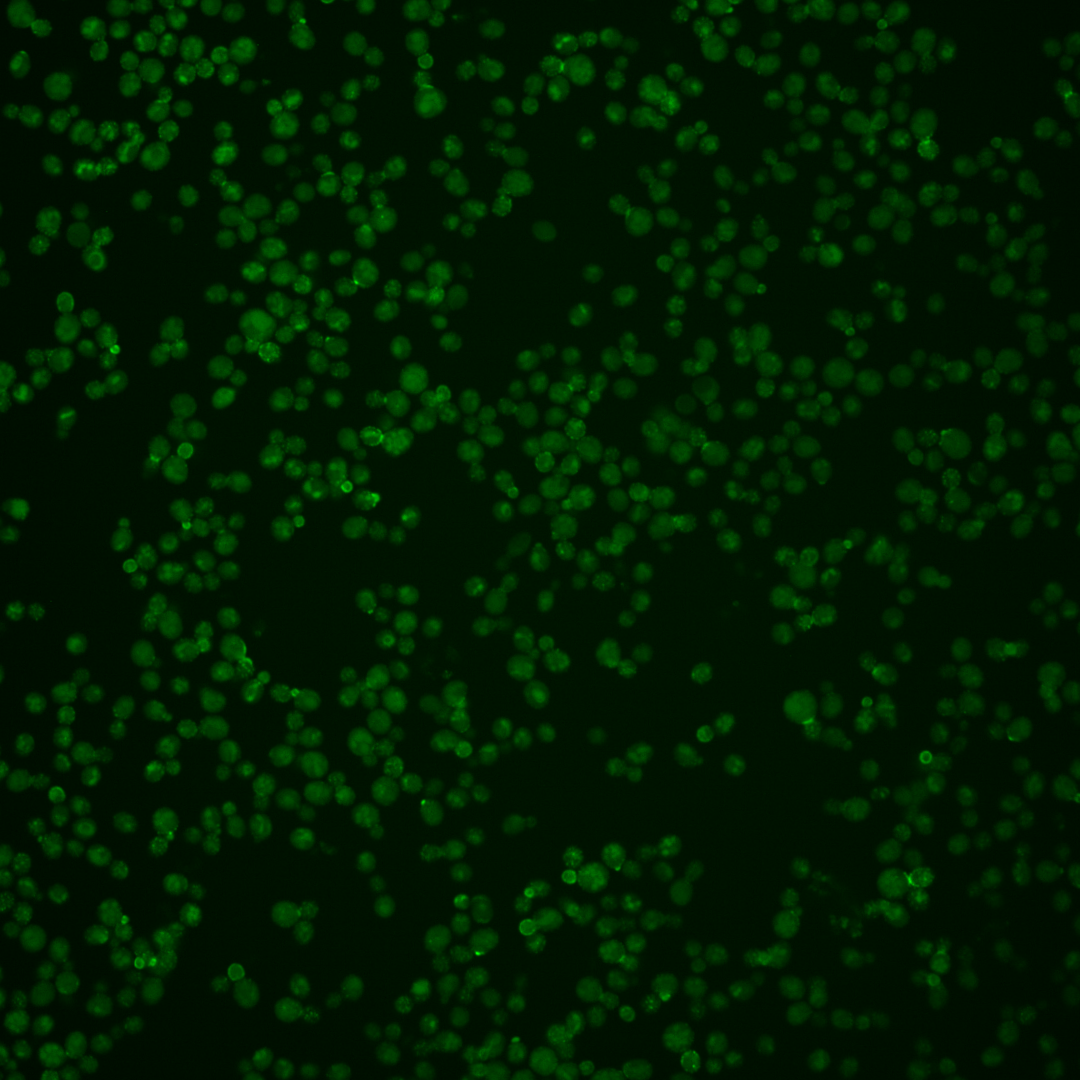
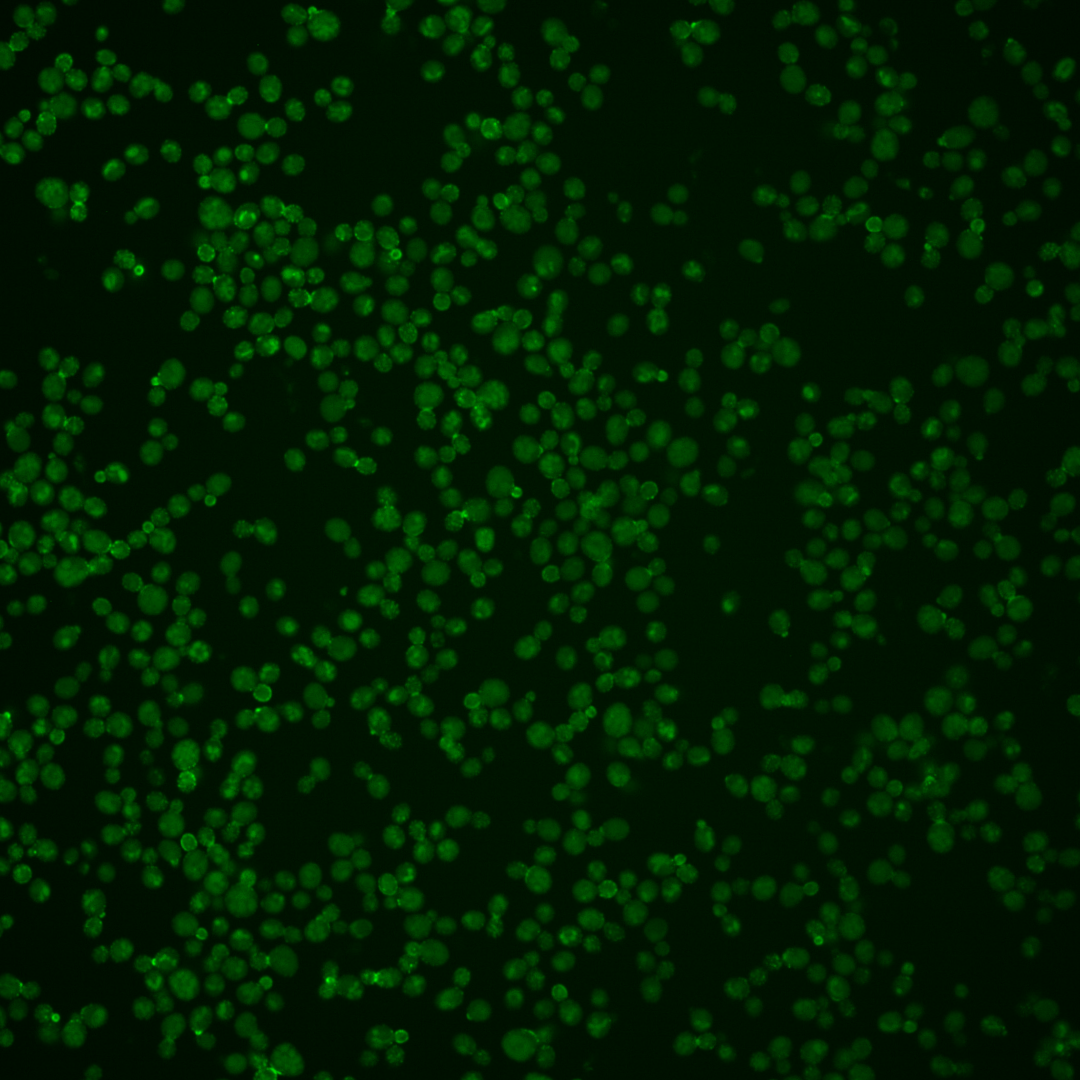

| ORF | |
|---|---|
| Human Ortholog | |
| Description | Protein of unknown function; green fluorescent protein (GFP)-fusion protein localizes to the cell periphery and vacuole; YOL019W has a paralog, DCV1, that arose from the whole genome duplication |
Micrographs




















































































Sub-cellular Localization
Yeast GFP Assignment
Protein Abundance
Localization Change
External localization resources
| ensLOC | DeepLoc | |||||||||||||||||||||||
|---|---|---|---|---|---|---|---|---|---|---|---|---|---|---|---|---|---|---|---|---|---|---|---|---|
| Localization | WT1 | WT2 | WT3 | RAP60 | RAP140 | RAP220 | RAP300 | RAP380 | RAP460 | RAP540 | RAP620 | RAP700 | HU80 | HU120 | HU160 | rpd3Δ_1 | rpd3Δ_2 | rpd3Δ_3 | WT1 | WT2 | WT3 | AF100 | AF140 | AF180 |
| Cortical Patches | 18 | 10 | 47 | 33 | 11 | 17 | – | 3 | 7 | 8 | 2 | 8 | 77 | 50 | 73 | – | 2 | – | 14 | 15 | 42 | 7 | 32 | 40 |
| Bud | 1 | 2 | 5 | 9 | 0 | 0 | – | 3 | 2 | 0 | 2 | 7 | 26 | 20 | 34 | – | 0 | – | 5 | 4 | 2 | 2 | 8 | 24 |
| Bud Neck | 0 | 0 | 0 | 0 | 0 | 0 | – | 0 | 0 | 0 | 0 | 0 | 0 | 1 | 3 | – | 0 | – | 5 | 8 | 4 | 1 | 4 | 6 |
| Bud Site | 2 | 0 | 1 | 0 | 1 | 0 | – | 1 | 0 | 0 | 0 | 0 | 0 | 2 | 3 | – | 0 | – | – | – | – | – | – | – |
| Cell Periphery | 6 | 3 | 12 | 11 | 6 | 8 | – | 1 | 8 | 7 | 4 | 3 | 33 | 33 | 41 | – | 0 | – | 1 | 0 | 5 | 2 | 4 | 1 |
| Cytoplasm | 8 | 8 | 12 | 26 | 35 | 56 | – | 99 | 152 | 151 | 161 | 161 | 54 | 126 | 187 | – | 0 | – | 0 | 3 | 1 | 1 | 1 | 2 |
| Endoplasmic Reticulum | 30 | 20 | 52 | 46 | 76 | 64 | – | 38 | 37 | 25 | 27 | 23 | 113 | 58 | 29 | – | 1 | – | 18 | 7 | 32 | 10 | 19 | 27 |
| Endosome | 0 | 1 | 2 | 3 | 0 | 0 | – | 1 | 3 | 2 | 0 | 4 | 7 | 2 | 1 | – | 0 | – | 0 | 7 | 1 | 0 | 2 | 5 |
| Golgi | 7 | 0 | 6 | 8 | 21 | 4 | – | 6 | 2 | 0 | 1 | 5 | 3 | 0 | 0 | – | 1 | – | 5 | 1 | 5 | 1 | 2 | 4 |
| Mitochondria | 6 | 8 | 9 | 4 | 10 | 4 | – | 17 | 19 | 19 | 26 | 10 | 2 | 0 | 0 | – | 0 | – | 4 | 4 | 7 | 6 | 13 | 8 |
| Nucleus | 18 | 4 | 14 | 19 | 9 | 39 | – | 145 | 110 | 97 | 62 | 66 | 17 | 17 | 8 | – | 3 | – | 0 | 0 | 0 | 0 | 0 | 0 |
| Nuclear Periphery | 2 | 1 | 1 | 0 | 2 | 2 | – | 2 | 7 | 1 | 0 | 2 | 0 | 1 | 0 | – | 0 | – | 0 | 1 | 0 | 0 | 1 | 1 |
| Nucleolus | 1 | 1 | 0 | 0 | 0 | 3 | – | 3 | 4 | 4 | 4 | 5 | 0 | 0 | 0 | – | 0 | – | 0 | 0 | 0 | 0 | 0 | 0 |
| Peroxisomes | 1 | 0 | 5 | 2 | 0 | 1 | – | 0 | 0 | 0 | 0 | 2 | 0 | 0 | 1 | – | 0 | – | 0 | 0 | 0 | 0 | 0 | 0 |
| SpindlePole | 0 | 0 | 2 | 2 | 0 | 0 | – | 0 | 0 | 0 | 0 | 0 | 2 | 6 | 12 | – | 1 | – | 0 | 0 | 0 | 0 | 0 | 0 |
| Vac/Vac Membrane | 77 | 16 | 114 | 101 | 206 | 225 | – | 501 | 395 | 378 | 321 | 348 | 90 | 50 | 33 | – | 14 | – | 103 | 57 | 171 | 30 | 46 | 53 |
| Unique Cell Count | 138 | 65 | 228 | 213 | 329 | 370 | 704 | 601 | 581 | 501 | 532 | 345 | 308 | 344 | 19 | 160 | 115 | 278 | 66 | 139 | 179 | |||
| Labelled Cell Count | 177 | 74 | 282 | 264 | 377 | 423 | 820 | 746 | 692 | 610 | 644 | 424 | 366 | 425 | 22 | 160 | 115 | 278 | 66 | 139 | 179 | |||
Yeast GFP Assignment
Protein Abundance
| Screen | WT1 | WT2 | WT3 | RAP60 | RAP140 | RAP220 | RAP300 | RAP380 | RAP460 | RAP540 | RAP620 | RAP700 | HU80 | HU120 | HU160 | rpd3Δ_1 | rpd3Δ_2 | rpd3Δ_3 | AF100 | AF140 | AF180 |
|---|---|---|---|---|---|---|---|---|---|---|---|---|---|---|---|---|---|---|---|---|---|
| Mean Cell GFP Intensity (1e-4) | 11.5 | 7.6 | 11.2 | 12.4 | 16.5 | 15.8 | – | 15.5 | 15.6 | 14.7 | 14.3 | 14.6 | 8.7 | 7.4 | 6.8 | – | 10.8 | – | 12.3 | 12.3 | 12.2 |
| Std Deviation (1e-4) | 3.2 | 2.2 | 3.1 | 2.9 | 3.6 | 3.0 | – | 3.5 | 3.5 | 3.5 | 3.5 | 3.6 | 1.6 | 1.5 | 1.3 | – | 1.8 | – | 3.1 | 2.8 | 3.0 |
| Intensity Change (Log2) | – | – | – | 0.15 | 0.56 | 0.5 | – | 0.47 | 0.47 | 0.39 | 0.35 | 0.38 | -0.36 | -0.6 | -0.71 | – | -0.05 | – | 0.14 | 0.13 | 0.13 |
Localization Change
| Localization | RAP60 | RAP140 | RAP220 | RAP300 | RAP380 | RAP460 | RAP540 | RAP620 | RAP700 | HU80 | HU120 | HU160 | rpd3Δ_1 | rpd3Δ_2 | rpd3Δ_3 |
|---|---|---|---|---|---|---|---|---|---|---|---|---|---|---|---|
| Cortical Patches | -1.4 | -6.6 | -6.2 | – | -11.8 | -10.1 | -9.8 | -10.1 | -9.3 | 0.5 | -1.3 | 0.2 | – | 0 | – |
| Bud | 1.2 | 0 | 0 | – | 0 | 0 | 0 | 0 | 0 | 2.8 | 2.3 | 3.6 | – | 0 | – |
| Bud Neck | 0 | 0 | 0 | – | 0 | 0 | 0 | 0 | 0 | 0 | 0 | 0 | – | 0 | – |
| Bud Site | 0 | 0 | 0 | – | 0 | 0 | 0 | 0 | 0 | 0 | 0 | 0 | – | 0 | – |
| Cell Periphery | 0 | -2.3 | -2.0 | – | 0 | -3.3 | -3.4 | -3.8 | 0 | 1.9 | 2.2 | 2.7 | – | 0 | – |
| Cytoplasm | 2.6 | 2.2 | 3.7 | – | 3.6 | 6.5 | 6.6 | 7.9 | 7.5 | 3.8 | 9.3 | 12.1 | – | 0 | – |
| Endoplasmic Reticulum | -0.3 | 0.1 | -1.7 | – | -7.7 | -6.9 | -8.1 | -7.0 | -7.8 | 2.6 | -1.1 | -4.8 | – | 0 | – |
| Endosome | 0 | 0 | 0 | – | 0 | 0 | 0 | 0 | 0 | 0 | 0 | 0 | – | 0 | – |
| Golgi | 0.7 | 2.0 | 0 | – | 0 | 0 | 0 | 0 | 0 | 0 | 0 | 0 | – | 0 | – |
| Mitochondria | -1.3 | -0.6 | 0 | – | -1.2 | -0.6 | -0.5 | 0.7 | -1.7 | 0 | 0 | 0 | – | 0 | – |
| Nucleus | 1.1 | -2.0 | 1.8 | – | 5.0 | 4.4 | 3.9 | 2.6 | 2.6 | -0.6 | -0.3 | -2.3 | – | 0 | – |
| Nuclear Periphery | 0 | 0 | 0 | – | 0 | 0 | 0 | 0 | 0 | 0 | 0 | 0 | – | 0 | – |
| Nucleolus | 0 | 0 | 0 | – | 0 | 0 | 0 | 0 | 0 | 0 | 0 | 0 | – | 0 | – |
| Peroxisomes | 0 | 0 | 0 | – | 0 | 0 | 0 | 0 | 0 | 0 | 0 | 0 | – | 0 | – |
| SpindlePole | 0 | 0 | 0 | – | 0 | 0 | 0 | 0 | 0 | 0 | 0 | 2.0 | – | 0 | – |
| Vacuole | -0.5 | 3.0 | 2.6 | – | 5.9 | 4.2 | 3.9 | 3.6 | 4.0 | -5.9 | -8.4 | -10.8 | – | 2.0 | – |
External localization resources
Images






























Protein Concentration and Protein Localization Data
| R1 | R2 | R3 | ||||||||||||||||
|---|---|---|---|---|---|---|---|---|---|---|---|---|---|---|---|---|---|---|
| G1 Pre-START | G1 Post-START | S/G2 | Metaphase | Anaphase | Telophase | G1 Pre-START | G1 Post-START | S/G2 | Metaphase | Anaphase | Telophase | G1 Pre-START | G1 Post-START | S/G2 | Metaphase | Anaphase | Telophase | |
| Concentration | 2.5426 | 3.1057 | 3.1627 | 2.5457 | 1.7561 | 3.2813 | 3.4632 | 3.9292 | 3.3494 | 3.2312 | 2.4931 | 3.521 | 2.8986 | 3.4159 | 3.0204 | 2.8864 | 2.9919 | 3.4075 |
| Actin | 0.0297 | 0.005 | 0.0196 | 0.0073 | 0.0009 | 0.0094 | 0.0637 | 0.0321 | 0.0471 | 0.0672 | 0.0011 | 0.018 | 0.0761 | 0.0109 | 0.0585 | 0.0277 | 0.0116 | 0.0141 |
| Bud | 0.0318 | 0.0176 | 0.0722 | 0.018 | 0.0259 | 0.0039 | 0.0107 | 0.0081 | 0.0345 | 0.0369 | 0.0052 | 0.0078 | 0.0157 | 0.0202 | 0.0579 | 0.0191 | 0.0333 | 0.0059 |
| Bud Neck | 0.0274 | 0.0119 | 0.013 | 0.0055 | 0.0245 | 0.2664 | 0.0546 | 0.019 | 0.0142 | 0.0272 | 0.06 | 0.2893 | 0.0385 | 0.0299 | 0.0295 | 0.0049 | 0.0209 | 0.3655 |
| Bud Periphery | 0.1144 | 0.0463 | 0.2673 | 0.1201 | 0.0952 | 0.0197 | 0.0384 | 0.0216 | 0.1726 | 0.3324 | 0.0285 | 0.0332 | 0.0694 | 0.0599 | 0.2005 | 0.1702 | 0.1551 | 0.0238 |
| Bud Site | 0.0566 | 0.1626 | 0.0374 | 0.0198 | 0.0199 | 0.0059 | 0.0892 | 0.2585 | 0.0636 | 0.0104 | 0.0068 | 0.0092 | 0.0611 | 0.1446 | 0.0536 | 0.0059 | 0.0164 | 0.0056 |
| Cell Periphery | 0.0418 | 0.03 | 0.0218 | 0.0204 | 0.0076 | 0.0221 | 0.0641 | 0.0347 | 0.0236 | 0.0348 | 0.0222 | 0.0273 | 0.0478 | 0.0234 | 0.021 | 0.0221 | 0.0617 | 0.0279 |
| Cytoplasm | 0.1595 | 0.0796 | 0.0746 | 0.1351 | 0.1937 | 0.1213 | 0.0862 | 0.1143 | 0.0766 | 0.014 | 0.1305 | 0.1066 | 0.1166 | 0.1092 | 0.087 | 0.1102 | 0.0789 | 0.0855 |
| Cytoplasmic Foci | 0.0405 | 0.0283 | 0.0135 | 0.0093 | 0.0214 | 0.0225 | 0.0377 | 0.039 | 0.0299 | 0.004 | 0.0109 | 0.021 | 0.0461 | 0.0343 | 0.02 | 0.0146 | 0.0115 | 0.0206 |
| Eisosomes | 0.0004 | 0.0002 | 0.0001 | 0.0001 | 0 | 0.0003 | 0.0045 | 0.0004 | 0.0006 | 0.0001 | 0.0001 | 0.0002 | 0.0013 | 0.0002 | 0.0004 | 0.0002 | 0.0007 | 0.0001 |
| Endoplasmic Reticulum | 0.0132 | 0.0144 | 0.0142 | 0.0214 | 0.0148 | 0.0109 | 0.0248 | 0.0091 | 0.0173 | 0.0204 | 0.013 | 0.0152 | 0.0176 | 0.0213 | 0.0109 | 0.0169 | 0.0382 | 0.0246 |
| Endosome | 0.1609 | 0.135 | 0.0779 | 0.1766 | 0.1809 | 0.104 | 0.0934 | 0.0838 | 0.119 | 0.0825 | 0.1005 | 0.1073 | 0.1473 | 0.1374 | 0.1071 | 0.1378 | 0.1486 | 0.073 |
| Golgi | 0.019 | 0.0177 | 0.0055 | 0.0122 | 0.0109 | 0.012 | 0.0311 | 0.0105 | 0.0229 | 0.0072 | 0.0055 | 0.0157 | 0.0204 | 0.0126 | 0.016 | 0.0078 | 0.0176 | 0.0096 |
| Lipid Particles | 0.0167 | 0.0159 | 0.0035 | 0.0057 | 0.0034 | 0.005 | 0.0484 | 0.0081 | 0.018 | 0.0032 | 0.0125 | 0.0082 | 0.0324 | 0.0229 | 0.0053 | 0.0041 | 0.0177 | 0.008 |
| Mitochondria | 0.0054 | 0.0061 | 0.0119 | 0.0084 | 0.006 | 0.0081 | 0.0118 | 0.0061 | 0.031 | 0.0199 | 0.0462 | 0.0065 | 0.0054 | 0.0064 | 0.0141 | 0.005 | 0.0092 | 0.0028 |
| None | 0.0202 | 0.0517 | 0.0523 | 0.0018 | 0.0043 | 0.014 | 0.0456 | 0.0823 | 0.0734 | 0.0008 | 0.0277 | 0.0093 | 0.0244 | 0.0522 | 0.0647 | 0.0601 | 0.0015 | 0.0043 |
| Nuclear Periphery | 0.0029 | 0.0025 | 0.0028 | 0.0052 | 0.0044 | 0.0021 | 0.0228 | 0.0028 | 0.0052 | 0.0044 | 0.0037 | 0.002 | 0.0051 | 0.0038 | 0.0029 | 0.0031 | 0.0056 | 0.0032 |
| Nucleolus | 0.0016 | 0.0034 | 0.0023 | 0.0018 | 0.0022 | 0.0016 | 0.0048 | 0.002 | 0.0015 | 0.0052 | 0.0023 | 0.0013 | 0.0014 | 0.0022 | 0.0017 | 0.0014 | 0.0013 | 0.0012 |
| Nucleus | 0.0028 | 0.0072 | 0.004 | 0.0054 | 0.0128 | 0.0038 | 0.0107 | 0.0037 | 0.0033 | 0.0071 | 0.007 | 0.0033 | 0.003 | 0.0047 | 0.0031 | 0.0033 | 0.0034 | 0.0031 |
| Peroxisomes | 0.0014 | 0.0014 | 0.0009 | 0.0003 | 0.0012 | 0.0008 | 0.0087 | 0.0029 | 0.0027 | 0.0004 | 0.0027 | 0.0008 | 0.0028 | 0.002 | 0.0013 | 0.0004 | 0.0005 | 0.0006 |
| Punctate Nuclear | 0.0006 | 0.0009 | 0.0006 | 0.0003 | 0.0008 | 0.001 | 0.0074 | 0.0008 | 0.0011 | 0.0002 | 0.0008 | 0.0005 | 0.002 | 0.001 | 0.0007 | 0.0003 | 0.0003 | 0.0004 |
| Vacuole | 0.2385 | 0.3478 | 0.2717 | 0.3892 | 0.3537 | 0.3457 | 0.2257 | 0.2512 | 0.2163 | 0.2868 | 0.4788 | 0.3049 | 0.2499 | 0.2782 | 0.2178 | 0.3492 | 0.3454 | 0.3097 |
| Vacuole Periphery | 0.0148 | 0.0145 | 0.0329 | 0.0364 | 0.0155 | 0.0195 | 0.0158 | 0.0092 | 0.0256 | 0.035 | 0.0338 | 0.0127 | 0.0157 | 0.0229 | 0.026 | 0.0356 | 0.0206 | 0.0104 |
Sequencing Data
| R1 | R2 | |||||||||
|---|---|---|---|---|---|---|---|---|---|---|
| G1 Post-START | S/G2 | Metaphase | Anaphase | Telophase | G1 Post-START | S/G2 | Metaphase | Anaphase | Telophase | |
| Gene Expression | 45.9752 | 21.443 | 17.2376 | 53.0974 | 51.4018 | 35.2947 | 22.7349 | 15.4461 | 36.7068 | 64.6492 |
| Translational Efficiency | 1.2398 | 1.4774 | 1.1829 | 0.8412 | 1.0008 | 1.434 | 0.8496 | 0.9949 | 1.0429 | 0.949 |
Hit Data
| Dataset | Hit |
|---|---|
| Protein Concentration | ✘ |
| Protein Localization | ✔ |
| Gene Expression | ✔ |
| Translational Efficiency | ✘ |
Endocytosis
| Temp | Actin Patch (Sac6-tdTomato) | Cortical Patch (Sla1-GFP) | Late Endosome (Snf7-GFP) | Vacuole (Vph1-GFP) |
|---|---|---|---|---|
| 37℃ | ||||
| RT |
Cell Cycle Omics
CYCLoPs (Yol019w-GFP)
| Gene / Allele | Actin Patch (Sac6-tdTomato) | Cortical Patch (Sla1-GFP) | Late Endosome (Snf7-GFP) | Vacuole (Sac6-tdTomato) |
|---|
| Gene | Images |
|---|
| Gene | Images |
|---|
Images are not yet available
Images are not yet available